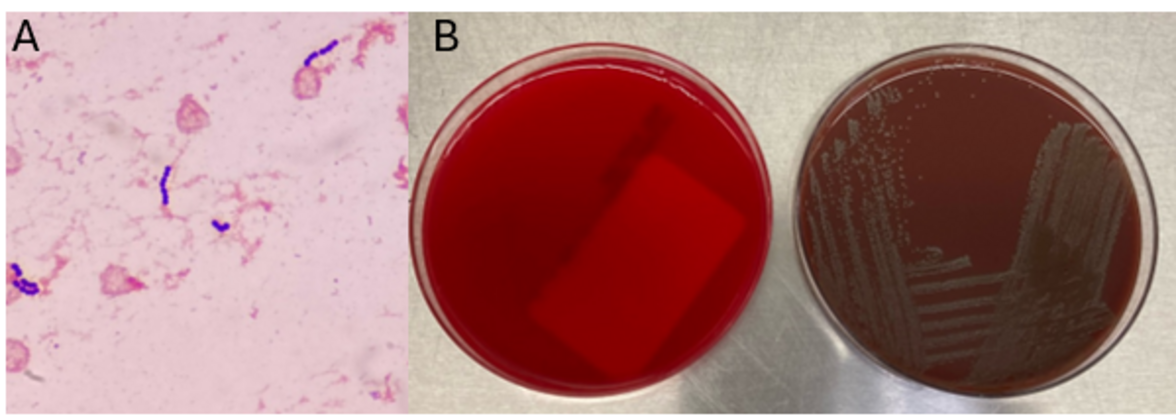

Мужчина 73 лет со сложным анамнезом, включающим диабет 1-го типа, ишемическую болезнь сердца, фибрилляцию предсердий, гипотиреоз, гиперлипидемию, глаукому, ранее перенесенную трансплантацию коронарных артерий, транскатетерную замену аортального клапана и имплантированный кардиовертер-дефибриллятор, поступил с двусторонними постоянными параспинальными болями в шее, ознобом и миалгиями.
Первоначальное обследование включало широкий спектр лабораторных и визуализационных исследований, которые показали умеренно повышенный уровень C-реактивного белка и СОЭ. Рентгенография грудной клетки, КТ головы/шеи и КТ грудной клетки были в норме. Пациент был выписан с симптомами, которые были устранены с помощью тайленола и валиума, и получил рекомендации по дальнейшему наблюдению. Через два дня пациент был повторно доставлен в отделение интенсивной терапии после того, как в культуре крови были обнаружены грамположительные кокки в парах и цепочках. Пациент, который на тот момент был бессимптомным, был проинформирован о результатах и согласился вернуться для дальнейшего обследования.
За месяц до этого пациент перенес удаление зуба с последующей установкой имплантата, что вызвало опасения по поводу эндокардита из-за протеза клапана и кардиостимулятора. Его перевели в кардиологическое отделение и назначили повторные посевы. Вначале пациент был афебрилен, но затем у него поднялась температура и его состояние осложнилось диабетическим кетоацидозом и септическим шоком, потребовавшим госпитализации в отделение интенсивной терапии. Пациента лечили ванкомицином внутривенно по 1,5 г каждые 24 часа и рекомендовали повторить посев крови. При выписке был поставлен диагноз: бактериемия, вызванная Abiotrophia defectiva, с возможным эндокардитом протезного клапана. Был назначен шестинедельный курс ванкомицина.
(A) Окраска по Граму положительного флакона с культурой крови выявила грамположительные кокки, расположенные цепочками и парами. (B) Инокуляция положительного флакона с культурой крови показала отсутствие роста на агаре с овечьей кровью, но рост на шоколадном агаре.
Обсуждение
Род Abiotrophia больше всего похож на хорошо известные грамположительные кокки в цепочках и парах, такие как стрептококки и энтерококки. Изначально считалось, что абиотрофии являются родственниками стрептококков группы viridans, но в результате секвенирования был выделен новый род Abiotrophia, состоящий из двух видов - A. defective и A. adiacens.
Abiotrophia классифицируется как питательно-вариантный стрептококк (NVS) и является частью нормальной флоры в кишечном тракте, ротовой полости и урогенитальном тракте. На долю этого микроорганизма приходится до 6% стрептококковых инфекционных эндокардитов и он ассоциируется с инфекцией нативных и протезных клапанов. Другие типы инфекций, описанные в связи с Abiotrophia, включают сепсис, инфекции глаз, центральной нервной системы, опорно-двигательного аппарата и артриты. Для своевременного и эффективного лечения крайне важно распознать A. defectiva, учитывая ее склонность вызывать тяжелые осложнения, такие как септическая эмболизация.
Абиотрофию относят к NVS, поскольку для роста на агаре с овечьей кровью этому микроорганизму требуются особые питательные вещества, такие как L-цистеин или пиридоксаль. Обычно они могут расти без добавок на шоколадном агаре, бруцелла-агаре с 5% лошадиной крови и в тиогликолатном бульоне. Иногда также можно использовать агар с овечьей кровью, дополненный пиридоксалем.
Благодаря высвобождению специфических питательных веществ лизированными эритроцитами для идентификации необходимо поставить дополнительный тест. Подозреваемый изолят высевают на агар не поддерживающий рост абиотрофов (например, агар с овечьей кровью), а затем перекрывают его поперечной полосой посева бета-гемолитического золотистого стафилококка. После инкубации колонии абиотрофии могут расти рядом с полоской S. aureus, что и дает эффект "спутника". Однако следует отметить, что другие привередливые организмы, такие как Granulicatella и некоторые виды Haemophilus, также могут расти вокруг полоски S. aureus. Следовательно, для идентификации необходимо дополнительное подтверждение. Например, Abiotrophia является неподвижной. Общие биохимические реакции, помогающие охарактеризовать род Abiotrophia, - это положительная реакция PYR (выработка пирролидонил-ариламидазы), положительная реакция LAP (выработка лейциновой аминопептидазы) и отсутствие роста при 6,5% NaCl.
Молекулярные методы доказали свою точность при идентификации Abiotrophia. Секвенирование гена 16S рРНК оказалось более точным, чем фенотипические и биохимические тесты. ПЦР-тестирование генов rpoB, groESL, а также рибосомального гена 16S-23S intergenic spacer region (ITS) показало, что все они являются надежными целями для идентификации. Внедрение масс-спектрометрии MALDI-TOF способствовало более точной идентификации в клинических условиях.
Для лечения инфекций, вызванных Abiotrophia defectiva, особенно у пожилых пациентов с сопутствующими заболеваниями, необходимы оперативная диагностика и целенаправленная антимикробная терапия. Раннее выявление и соответствующее лечение жизненно важны для смягчения возможных осложнений. Виды Abiotrophia демонстрируют различную чувствительность к антибиотикам, с растущей резистентностью к пенициллину. Обычные методы лечения включают пенициллин, цефтриаксон и ванкомицин.
